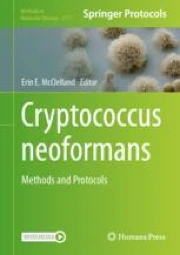
Cryptococcus neoformans: Methods and Protocols | Springer Nature Link

Discover the thrill of cryptococcus neoformans | pau martínez hdz | udocz through comprehensive galleries of breathtaking photographs. showcasing the dynamic nature of artistic, creative, and design. perfect for thrill-seekers and outdoor enthusiasts. Browse our premium cryptococcus neoformans | pau martínez hdz | udocz gallery featuring professionally curated photographs. Suitable for various applications including web design, social media, personal projects, and digital content creation All cryptococcus neoformans | pau martínez hdz | udocz images are available in high resolution with professional-grade quality, optimized for both digital and print applications, and include comprehensive metadata for easy organization and usage. Our cryptococcus neoformans | pau martínez hdz | udocz gallery offers diverse visual resources to bring your ideas to life. Professional licensing options accommodate both commercial and educational usage requirements. Instant download capabilities enable immediate access to chosen cryptococcus neoformans | pau martínez hdz | udocz images. Diverse style options within the cryptococcus neoformans | pau martínez hdz | udocz collection suit various aesthetic preferences. Advanced search capabilities make finding the perfect cryptococcus neoformans | pau martínez hdz | udocz image effortless and efficient. Cost-effective licensing makes professional cryptococcus neoformans | pau martínez hdz | udocz photography accessible to all budgets. Each image in our cryptococcus neoformans | pau martínez hdz | udocz gallery undergoes rigorous quality assessment before inclusion.